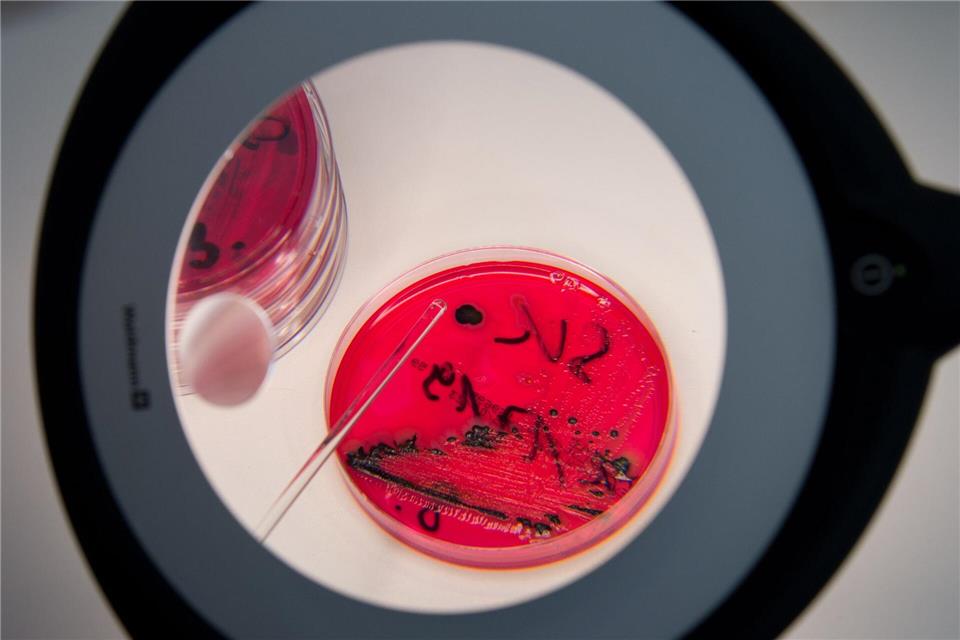
Wegen Salmonellen ruft der Hersteller Dog’s Nature GmbH Schweineohren ohne Muschel für Hunde zurück. (Symbolbild)Arno Burgi/dpa-Zentralbild/dpa

Hundefutter bei Kaufland zurückgerufen
Hundehalter müssen achtgeben: In Schweineohren, die bei Kaufland verkauft wurden, sind Salmonellen festgestellt worden. Das könnte auch für Menschen gefährlich sein.
Wegen Salmonellen ruft der Hersteller Dog’s Nature GmbH Schweineohren ohne Muschel für Hunde zurück. (Symbolbild)Arno Burgi/dpa-Zentralbild/dpa
© Arno Burgi/dpa-Zentralbild/dpa
Der Hersteller Dog’s Nature ruft das Produkt „K-Carinura Naturals Schweineohren ohne Muschel für Hunde 2 Stk., GTIN 4063367568275“ zurück. Betroffen sind Packungen mit Mindesthaltbarkeitsdatum und Losnummer: 09/2027 0-248-25S, wie Kaufland mitteilte. Die Produkte wurden bei Kaufland verkauft. Kunden können sie in allen Filialen zurückgeben und sollen sie nicht verfüttern.
In den Produkten wurden Salmonellen nachgewiesen. Bei geschwächten oder empfindlichen Hunden könnten Durchfall, Fieber oder Erbrechen auftreten, hieß es. In seltenen Fällen seien auch schwerere Krankheitsverläufe möglich. Durch den Kontakt mit dem kontaminierten Produkt bestehe auch ein Infektionsrisiko für Hundehalter.
Menschen können bei einer Salmonellen-Erkrankung Durchfall, Bauchschmerzen, Erbrechen und leichtes Fieber bekommen. Insbesondere Säuglinge, Kleinkinder, Senioren und Menschen mit geschwächtem Abwehrsystem können schwerere Krankheitsverläufe entwickeln.


